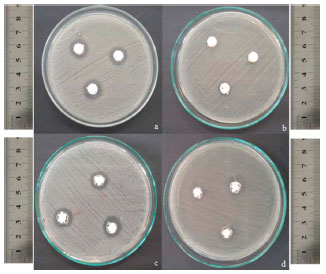

Artigo
|
|
| Polímero biodegradável antimicrobiano através da aditivação com compostos à base de zinco Antimicrobial biodegradable polymer through additivation with zinc based compounds |
|
Ana P. CapelezzoI,*,#; Laura C. MohrI,#; Francieli DalcantonI,x; Carolina R. D. M. BarretaI,#; Maria A. P. M. MartinsII; Márcio A. FioriI,#,x; Josiane M. M. de MelloI,#,x
I. Universidade Comunitária da Região de Chapecó, Chapecó - SC, Brasil Recebido em 06/07/2017 * e-mail: ana_cap@unochapeco.edu.br Antimicrobial packaging is a promising type of active packaging, which has an antimicrobial agent incorporated into the polymer matrix, capable to eliminate or inhibit deteriorating and/or pathogenic microorganisms. The zinc compounds are antimicrobial agents commonly used to confer this feature. The objective of this work was to evaluate the antimicrobial activity of biodegradable Ecoflexr films with 1% and 2% (w/w) zinc oxide nanoparticles (ZnO NPs) and 1% and 2% (w/w) glass microparticles doped with ionic zinc (Zn MCs), against Staphylococcus aureus and Escherichia coli. The sample's biodegradation in soil also were studied. Microbiological results showed that biodegradable polymeric films obtained were effective to inhibit and/or kill S. aureus and E. coli at the initial concentration of 104 CFU.mL-1 after 24 h of contact. When evaluated the biodegradation of the polymers containing the additives, the results showed that the addition of zinc compounds to the biodegradable polymer did not affect its biodegradability characteristic. The antimicrobial biodegradable films developed have potential application to the food packaging industry. INTRODUÇAO A necessidade de prolongar a vida útil dos alimentos demanda pesquisas e inovaçoes que ofereçam soluçoes no segmento de embalagens, por isso essa temática apresenta um significativo crescimento e relevância. Tendências atuais sugerem o desenvolvimento de embalagens funcionais contendo agentes antimicrobianos capazes de inibir ou até mesmo causar a morte de microrganismos deteriorantes e/ou patogênicos e embalagens ambientalmente favoráveis às quais possuem um baixo nível de impacto ambiental.1 O controle dos agentes deteriorantes e/ou patogênicos torna-se indispensável, garantindo que alimentos de qualidade cheguem aos consumidores finais. Assim, o emprego de embalagens antimicrobianas, as chamadas embalagens ativas, apresenta-se como uma alternativa interessante no que diz respeito à preservaçao dos alimentos. Estas embalagens ativas contribuem para o retardo do processo de deterioraçao, aumentando a vida útil dos alimentos acondicionados, proporcionando a manutençao da qualidade e segurança alimentar.2-5 O uso de micropartículas e nanopartículas antimicrobianas tem se mostrado uma alterativa promissora no controle da contaminaçao de alimentos ocasionada por bactérias e fungos patogênicos. Este controle é de grande interesse para a saúde pública e para mitigar grandes prejuízos econômicos devido ao descarte prematuro dos alimentos contaminados por estes microrganismos nocivos à saúde humana e animal.4,6 Deste modo, recomenda-se a incorporaçao de agentes antimicrobianos à diferentes matrizes poliméricas empregadas na fabricaçao de embalagens de alimentos, de modo a inibir ou até mesmo matar os microrganismos presentes em alimentos e demais superfícies contaminadas. Existem diversos tipos de partículas de óxidos metálicos e íons que podem ser aplicados para tal finalidade, como exemplo cita-se íons ou nanopartículas de prata (Ag), ouro (Au), cobre (Cu), dióxido de titânio (TiO2), óxido de magnésio (MgO), óxido de cálcio (CaO) e óxido de zinco (ZnO). Tanto na forma de micropartículas, quanto de nanopartículas, ou de espécies iônicas, estas podem ser aplicadas como aditivos antimicrobianos em diferentes materiais poliméricos.5,7,8 Especialmente na forma de nanopartículas, podem revelar ou magnificar as propriedades antibacteriana e antifúngica devido, principalmente, ao seu pequeno tamanho e grande área superficial específica. Em particular, os compostos de zinco têm se mostrado eficientes agentes antimicrobianos e, ainda, têm despertado interesse devido algumas propriedades multifuncionais e características importantes, como o efeito fotocatalítico, a sua atoxicidade em concentraçoes relativamente elevadas e o seu baixo custo. O ZnO, por exemplo, é classificado em um grupo de agentes antimicrobianos inorgânicos altamente seguros e extremamente estáveis termicamente, quando comparado aos agentes antimicrobianos orgânicos.9-12 Essas espécies interagem com a parede celular bacteriana resultando na destruiçao da integridade celular, por mecanismos de liberaçao de íons de zinco (Zn2+), diferenças de potencial elétrico relativamente elevadas e a formaçao de espécies reativas de oxigênio.12 Na forma de nanopartículas, possui vantagens devido à relaçao volume/área, o que garante a manutençao da atividade antimicrobiana mesmo na presença de pequena quantidade de espécies.13 As microcápsulas de vidro dopadas com zinco iônico, por sua vez, possuem o princípio de açao antimicrobiana atribuído em funçao do Zn2+ e permite excelentes distribuiçoes em diferentes matrizes e elevada atividade antimicrobiana.7,8 Já existem no mercado diversos polímeros convencionais com propriedades antimicrobianas e sendo aplicados em embalagens.5,7,8,14-19 Porém, devido à biodegradaçao lenta pelo meio ambiente dessa classe de polímeros é que se preconiza o estudo e aplicaçao de polímeros biodegradáveis. A proposta de adicionar compostos antimicrobianos em polímeros biodegradáveis tem como objetivo principal aumentar a vida útil de produtos alimentícios, cosméticos e medicamentos, mas utilizando esta classe de polímeros como um diferencial ambiental. Porém, a açao antimicrobiana deverá ser agregada sem causar prejuízos significativos nas propriedades de biodegradaçao da matriz polimérica. O poli (butileno adipato co-tereftalato) (PBAT) é um polímero biodegradável que vem sendo estudado e sugerido para a fabricaçao de embalagens. Pertence à classe dos co-poliésteres alifáticos aromáticos chamado comercialmente de Ecoflex®, constituído por dois tipos de dímeros, um de seçao rígida formada por uma unidade de repetiçao de éster que consiste em 1,4 butanodiol e os monômeros de ácido tereftálico; e outro de seçao flexível, que consiste em 1,4 butanodiol e monômeros de ácido adípico.20 O PBAT possui propriedades semelhantes ao Polietileno de Baixa Densidade (PEBD) devido a sua alta massa molecular e estrutura química de cadeia longa ramificada. Possui características como elasticidade, resistência à água e à ruptura, processável em plantas de filme soprado convencionais como o Polietileno (PE), imprimíveis, soldáveis e adequados para contato com alimentos.21 O polímero biodegradável PBAT vem sendo proposto22,23 como um bom polímero biodegradável para uso em embalagens. Porém, como polímero antimicrobiano por aditivaçao com compostos à base de zinco praticamente nao há trabalhos tecnológicos e científicos tratando do tema ainda. Um dos poucos trabalhos relata o desenvolvimento de filmes de PBAT/NPs-ZnO (nanopartículas de óxido de zinco) e avalia as propriedades mecânicas e microbiológicas frente às bactérias Escherichia coli (E. coli) e Staphylococcus aureus (S. aureus), mas nao avalia o efeito na biodegradabilidade.24 A literatura apresenta alguns trabalhos que fazem o uso de outros polímeros biodegradáveis e compostos de zinco para a obtençao de filmes antimicrobianos, porém em um número consideravelmente muito menor do que os polímeros convencionais.25-28 Este artigo reporta a preparaçao, caracterizaçao e comparaçao de filmes de Ecoflex®/NPs-ZnO e de Ecoflex®/MCs-Zn (microcápsulas de vidro dopadas com zinco iônico) com percentuais de 1 e 2% (m/m) em relaçao à propriedade antimicrobiana e de biodegradaçao. Para as avaliaçoes microbiológicas os filmes foram testados com bactérias E. coli e S. aureus.
PARTE EXPERIMENTAL Materiais O Ecoflex® possui ponto de fusao de 110-120 ºC, densidade de 1,25-1,27 g cm-3 e massa molar de 14,2x104 g mol-1 dados estes fornecidos pela BASF. As NPs-ZnO e as MCs-Zn foram gentilmente fornecidas pela Kher Group. As NPs-ZnO possuem formato de bastao com diâmetro médio de aproximadamente 20 nm e com diferentes comprimentos que podem atingir valores de até 200 nm. As MCs-Zn sao constituídas por micropartículas com dimensoes entre 1 mm e 10 mm e formatos irregulares. Métodos Atividade antimicrobiana das NPs-ZnO e MCs-Zn A atividade antimicrobiana das NPs-ZnO e MCs-Zn foi avaliada contra S. aureus (ATCC 25923) e E. coli (ATCC 8739) usando o método de halo de inibiçao conforme as recomendaçoes do Clinical and Laboratory Standards Institute.29 Os testes foram realizados em triplicata. As placas foram incubadas em estufa bacteriológica (marca Quimis, modelo Q316m5) a 37±1 ºC por 24 h e posteriormente foram mensurados os diâmetros dos halos de inibiçao de acordo com a Equaçao 1.  sendo: Dex: diâmetro externo formado pela açao do agente antimicrobiano sobre os microrganismos (mm) Din: diâmetro ocupado pelo agente antimicrobiano (mm). Os resultados foram submetidos ao teste de Tukey de modo a avaliar a existência de diferenças significativas ao nível de significância 5% (p < 0,05). Preparaçao dos filmes poliméricos biodegradáveis Os aditivos antimicrobianos, NPs-ZnO e MCs-Zn, foram secos em estufa (marca Cid, modelo 311 cg), sob temperatura de 70 ºC durante 1 h. Tanto as NPs-ZnO, quanto as MCs-Zn foram misturadas manualmente com os pellets de Ecoflex® em um béquer utilizando um bastao de vidro nas concentraçoes de 1 e 2% (m/m), até a completa homogeneizaçao. Após, o processamento foi realizado em uma extrusora industrial monorosca (marca Oryzon), que possui sete zonas de aquecimento, sendo que as quatro primeiras foram mantidas à 130 ºC e as demais à 145 ºC. A velocidade de rotaçao da rosca foi de 85 rpm. Atividade antimicrobiana dos filmes poliméricos As amostras dos filmes poliméricos foram submetidas ao teste de contagem de microrganismos sobreviventes com o tempo (curva de morte), de acordo com a norma internacional JIS Z 2801 (2010).30 O objetivo desta análise foi avaliar a capacidade de inibiçao do crescimento ou morte das bactérias na superfície das amostras de filmes poliméricos. As suspençoes bacterianas de S. aureus e E. coli foram cultivadas em caldo Brain Heart Infusion (BHI, marca Himedia) durante 24 h a 37±1 ºC e após ajustadas em soluçao de cloreto de sódio (NaCl, marca Merck) a 0,85% para uma concentraçao de 104 UFC mL-1. Para tal, utilizou-se um espectrofotômetro (marca Bel photonics, modelo 1105) no comprimento de onda de 619 nm, sendo que para se obter tal concentraçao de microrganismos a absorbância lida no equipamento deveria estar entre 0,04 e 0,049. O preparo da amostra consistiu na adiçao de 40 µL da suspensao bacteriana a cada corpo de prova (4x4 cm) e adiçao de 1 mL de soluçao de NaCl a 0,85% ao redor de cada um destes. Uma lamínula de vidro estéril foi colocada sobre cada corpo de prova a fim de espalhar a alíquota de bactérias por toda extensao dos mesmos. Após, as placas foram encaminhadas à estufa bacteriológica à 37±1 ºC por um período de tempo de 0, 1, 3, 6 e 24 h. Em cada tempo retirou-se uma amostra da estufa, e esta foi inserida em um saco de stomacher (marca Nazco whirl-pak) juntamente com 10 mL de soluçao de NaCl a 0,85% e, entao, homogeneizada por aproximadamente 1 min (amostra 100). A partir desta foram feitas duas diluiçoes seriadas. Retirou-se 0,1 mL do saco de stomacher e das respectivas diluiçoes que foram semeados em profundidade juntamente com 7 mL caldo Mueller Hinton (marca Merck). As placas de petri foram homogeneizadas e incubadas em estufa bacteriológica na posiçao invertida a 37±1 ºC por um período de 24 h. Repetiu-se o procedimento para todos os tempos de análise, sendo que os ensaios foram realizados em triplicata. Após decorridas as 24 h de incubaçao, as placas amostradas foram retiradas da estufa bacteriológica para realizaçao da contagem das Unidades Formadoras de Colônias por cm2 (UFC cm-2). As placas com quantidade de colônias entre 30 e 300 foram submetidas à contagem e o número de bactérias viáveis por cm2 foi determinado de acordo com a Equaçao 2.  sendo: N: número de bactérias viáveis por cm-2, C: número de colônias (UFC cm-2), D: fator de diluiçao (adimencional); V: volume (mL) de soluçao de NaCl a 0,85% usada para lavagem da amostra (10 mL) e A: área superficial (16 cm2). Os resultados foram submetidos ao teste de Tukey de modo a avaliar a existência de diferenças significativas ao nível de significância 5% (p < 0,05). Estes foram expressos em quantidade normalizada de colônias bacterianas por cm2 de amostra. Teste de Biodegradaçao O ensaio de biodegradaçao foi realizado conforme as normas da Americam Society for Testing and Materials através da ASTM D-5988-12 (Standard Test Method for Determining Aerobic Biodegradation of Plastic Materials in Soil)31 e ASTM D 5338-11 (Standard test method for determining aerobic biodegradation of plastic materials under controlled composting conditions, incorporating thermophilic temperatures)32 com adaptaçoes propostas por Mariani et al.33 O solo utilizado no ensaio de biodegradaçao foi de uma floresta, caracterizado como latossolo, localizado na regiao da cidade de Chapecó - SC, no mês de outubro de 2016. A coleta foi realizada na profundidade de 10 cm em relaçao à camada superficial. Este solo foi peneirado para uma granulometria de 2 mm, e sua umidade foi determinada em estufa (marca Quimis, modelo Q314M252) à uma temperatura de 105 ºC por 72 h (até obtençao de massa constante), utilizando-se 50 g de amostra, sendo que este ensaio foi realizado em triplicata. A umidade do solo foi ajustada para 60% da capacidade máxima de retençao (CRA) e a metodologia utilizada para determinaçao da capacidade máxima de retençao foi a ISO 17512-2,34 sendo este ensaio também realizado em triplicata. A determinaçao de nitrogênio, carbono orgânico e relaçao C/N foi realizada pelo laboratório de solos da Epagri - SC. Dentro de cada frasco de vidro de 3 L foram colocadas porçoes de 200 g de solo in natura, juntamente com uma amostra de cada filme polimérico (2x2 cm) enterrados na porçao de solo, um frasco de vidro snap cap contendo 10 mL de uma soluçao de hidróxido de sódio (NaOH, marca Merck) 0,5 mol L-1 e outro contendo 30 mL de água destilada. Os frascos de vidro foram vedados utilizando um filme de PVC (Poli cloreto de vinila), de modo a nao haver interferência do gás carbônico (CO2) do ar. O ensaio de biodegradaçao foi realizado com os dois filmes poliméricos aditivados com NPs-ZnO (1 e 2%), os dois filmes poliméricos aditivados com MCs-Zn (1 e 2%) e com o filme polimérico sem aditivo. Frascos de vidro contendo apenas solo foram usados como branco. Todos os ensaios foram realizados em triplicata. Os frascos de vidro foram incubados em uma estufa incubadora de Demanda Bioquímica de Oxigênio (DBO, marca Dist) a uma temperatura de 28±2 ºC e na ausência de luz. A cada 3 dias os recipientes de vidro foram retirados da estufa e 1 mL de uma soluçao de Cloreto de bário (BaCl2, marca Dinâmica) 0,5 mol L-1 foi adicionado em cada um dos respetivos snap caps, que continham NaOH. Este procedimento proporcionou a precipitaçao do carbonato de bário resultante da reaçao do carbonato formado com o bário adicionado, possibilitando desta forma a quantificaçao do CO2 gerado no processo de biodegradaçao, sem nenhum interferente. Os snap caps foram retirados do interior dos recipientes de vidro e aguardado um período de 30 minutos para a decantaçao do carbonato de bário. O NaOH remanescente, que nao reagiu com o CO2, foi titulado com ácido clorídrico (HCl, marca Vetec) 0,5 mol L-1, padronizado conforme descrito por Morita e Assumpçao,35 utilizando como indicador a fenolftaleína 1%. A soluçao de NaOH foi reposta nos snap caps, e estes foram novamente inseridos nos recipientes de vidro, fechados com filme de PVC e levados novamente a estufa incubadora DBO. Através da relaçao estequiométrica foi possível calcular a quantidade de CO2 produzida no processo de biodegradaçao dos materiais poliméricos, conforme mostra a Equaçao 3.  sendo: mCO2: massa de CO2 produzido no processo de biodegradaçao (mg); VHCl: volume de ácido clorídrico gasto na titulaçao (mL); 0,5: normalidade do HCl; 22: equivalente grama do CO2. Para garantir que a umidade do solo ficasse acima de 60% durante todo o experimento, após decorridos 30 dias adicionou-se 2 mL de água destilada no solo a cada 6 dias, sendo este procedimento realizado até os 90 dias de ensaio. A comparaçao da quantidade de CO2 produzida pelos diferentes filmes poliméricos foi avaliada empregando o método estatístico de Tukey com significância de 5% (p < 0,05). No instante inicial e após 90 dias de ensaio de biodegradaçao uma amostra de cada filme polimérico, mantida nas mesmas condiçoes dos demais testes, foi analisada por microscopia óptica (MO), utilizando um estereoscópio (marca Tecnival, modelo binocular SQZDS4BI70) com aumento de 50 vezes. Após 90 dias de ensaio de biodegradaçao as amostras foram lavadas com água destilada e secas naturalmente, e posteriormente analisadas por microscopia óptica.
RESULTADOS E DISCUSSAO Atividade antimicrobiana das NPs-ZnO e MCs-Zn Os ensaios de inibiçao microbiológica mostraram atividade antimicrobiana por difusao em meio sólido dos aditivos NPs-ZnO e MCs-Zn, com a formaçao de halos de inibiçao para ambos, conforme pode ser observado na Figura 1. Com as NPs-ZnO frente à S. aureus e E. coli os halos de inibiçao foram de 7,3±0,6 mm e 2,0±1,0 mm, respectivamente. Com as MCs-Zn o valor dos halos de inibiçao foram de 7,0±1,0 mm e 4,7±2,1 mm, respectivamente.
Figura 1. Resultados dos testes de difusao em meio sólido a partir de orifício para as NPs-ZnO e MCs-Zn. (a) NPs-ZnO/S. aureus, (b) NPs-ZnO/E. coli, (c) MCs-Zn/S. aureus, (d) MCs-Zn/E. coli
É possível constatar que tanto para as NPs-ZnO quanto para as MCs-Zn os maiores halos de inibiçao sao observados para a bactéria gram-positiva S. aureus, resultado já esperado, pois as células bacterianas gram-positivas possuem apenas uma camada exterior como membrana plasmática, o que facilita a penetraçao de compostos antimicrobianos e a interaçao com o citoplasma bacteriano, tornando as gram-positivas mais susceptíveis quando comparadas as gram-negativas. As bactérias gram-negativas possuem uma membrana adicional, formando uma estrutura de bicamada fosfolipídica mais resistente que aumenta a proteçao citoplasmática de agentes antimicrobianos, a exemplo da bactéria E. coli.36 A maior resistência da bactéria E. coli, em relaçao a S. aureus, pode também ser possivelmente atribuída à diferença na polaridade da membrana celular, uma vez que a membrana da S. aureus tem carga negativa menor quando comparada à membrana da E. coli.37 Com diferenças menores de carga é possível maiores fluxos de penetraçao de radicais livres, tais como radicais hidroxila, superóxido e íons peróxido, para o citoplasma. Este efeito conduz com maior facilidade a morte celular das bactérias S. aureus em relaçao a E. coli.38 Além disso, vários fatores podem afetar a atividade antimicrobiana, entre os quais o tamanho das nanopartículas e, desta forma, a área de superfície, bem como a sua atividade em sinergia com outros agentes antimicrobianos.4 Quando comparados os diferentes aditivos antimicrobianos frente à mesma bactéria, observou-se com análises estatísticas, que nao houve diferença significativa entre ambos. Ou seja, um efeito antimicrobiano muito semelhante é observado para as NPs-ZnO e MCs-Zn quando estudada a mesma estirpe bacteriana. Atividade antimicrobiana dos filmes poliméricos As Figuras 2 e 3 apresentam os resultados microbiológicos obtidos com curvas de morte, para as bactérias S. aureus e E. coli, respectivamente, para os filmes poliméricos de Ecoflex® aditivados com 1 e 2% (m/m) de NPs-ZnO. O filme polimérico de Ecoflex® puro também foi submetido a este ensaio microbiológico.
 Figura 2. Curva de morte obtida com os filmes poliméricos de Ecoflex® aditivados com 1 e 2% (m/m) de NPs-ZnO e para o filme polimérico de Ecoflex® puro frente a bactéria S. aureus
 Figura 3. Curva de morte obtida com os filmes poliméricos de Ecoflex® aditivados com 1 e 2% (m/m) de NPs-ZnO e para o filme polimérico de Ecoflex® puro frente a bactéria E. coli
Os resultados apresentados na Figura 2 comprovam que os filmes poliméricos aditivados apresentaram atividade antimicrobiana contra a bactéria S. aureus. Verifica-se que com a maior concentraçao de aditivo (2% m/m), a partir de 6 h de contato com os microrganismos, ocorre a reduçao de 100,0±0% das bactérias. Com o filme polimérico aditivado com 1% (m/m) de NPs-ZnO a reduçao é de 99,7±0,5% após 24 h, o que também pode ser considerado um ótimo desempenho antibacteriano. A partir da análise estatística verifica-se que nao há diferenças significativas da atividade antibacteriana após 24 horas entre os filmes aditivados com as duas concentraçoes de nanopartículas. Notoriamente observa-se que o filme puro de Ecoflex® nao apresenta atividade antibacteriana. Os filmes aditivados com 1% de NPs-ZnO proporcionaram desvio relativamente grande para os resultados de curva de morte, possivelmente associados à pequena quantidade de nanopartículas, à dispersao nao homogênea ao longo da matriz polimérica e à formaçao de aglomerados. A atividade antimicrobiana dos filmes poliméricos aditivados com diferentes percentuais de NPs-ZnO pode ser prejudicada devido a uma possível aglomeraçao das NPs-ZnO ao longo da matriz polimérica, que pode promover a formaçao de clusters localizados em regioes específicas das amostras.8 Para o Ecoflex® puro a quantidade de bactérias após 24 h de análise é muito semelhante à quantidade inicial, mostrando que este polímero sem a aditivaçao nao apresenta propriedade antibacteriana. Porém, nas primeiras horas de contato das bactérias com o filme polimérico houve uma reduçao da contagem de células bacterianas, possivelmente devido à adaptaçao das mesmas no filme polimérico, que gera um estresse levando algumas células à morte. Esse comportamento pode ser visualizado nas Figuras 2 a 5.
 Figura 4. Curva de morte obtida com os filmes poliméricos de Ecoflex® aditivados com 1 e 2% (m/m) de MCs-Zn e para o filme polimérico de Ecoflex® puro frente a bactéria S. aureus
 Figura 5. Curva de morte obtida com os filmes poliméricos de Ecoflex® aditivados com 1 e 2% (m/m) de MCs-Zn e para o filme polimérico de Ecoflex® puro frente a bactéria E. coli
A Figura 3 mostra as curvas de morte obtidas com a bactéria E. coli. Os resultados indicam uma queda brusca na quantidade de colônias bacterianas próximas de zero nas primeiras horas de contato com o filme polimérico. Após 24 horas, a reduçao atinge valores percentuais de reduçao próximo a 77,5±1,8% para os filmes poliméricos aditivados com 1% (m/m) de NPs-ZnO e de 99,1±1,2% para os filmes aditivados com 2% (m/m) de NPs-ZnO. Com o percentual de aditivaçao avaliado nao foi possível causar a morte da totalidade das células bacterianas, possivelmente por se tratar de bactérias gram-negativas e por isso serem mais resistentes que S. aureus.36 A partir da análise estatística verificou-se que o efeito antimicrobiano do filme de Ecoflex® puro diferiu estatisticamente dos filmes aditivados com 1 e 2% (m/m) de NPs-ZnO e que houve diferença estatisticamente significativa entre os percentuais de aditivos. Logo, quando avaliada a propriedade antibacteriana frente à bactéria E. coli é necessária uma quantidade de aditivo maior para inibir o crescimento das células bacterianas acima de 99,0%, efeito observado com a menor concentraçao de aditivo quando estudada a bactéria S. aureus. Kirschner et al.8 estudaram a incorporaçao do masterbatch de PEBD preparados com NPs-ZnO em Poliamida 6 (PA6) e testaram sua atividade antimicrobiana frente à Salmonella typhimurium (S. typhimurium) e S. aureus. Os autores verificaram que a atividade antibacteriana foi eficiente, porém foi observada uma elevada dispersao para os valores medidos. A alta dispersao pode ser associada a uma possível falta de homogeneizaçao na matriz da PA6-PEBD/NPs-ZnO. As nanopartículas formaram aglomerados e dessa forma a distribuiçao das mesmas ficou prejudicada, impossibilitando que a atividade antimicrobiana fosse verificada em toda a extensao da placa. As Figuras 4 e 5 apresentam as curvas de morte obtidas para os filmes poliméricos de Ecoflex® aditivados com 1 e 2% (m/m) de MCs-Zn, com as bactérias S. aureus e E. coli, respectivamente, além do filme polimérico de Ecoflex® puro (branco). Os filmes aditivados com 1% (m/m) de MCs-Zn, após 6 horas, reduzem consideravelmente a quantidade de colônias bacterianas de S. aureus, sendo que em 24 h ocorre a inibiçao total. Com os filmes aditivados com 2% (m/m) de MCs-Zn observa-se, após 1 hora, a inibiçao total das colônias bacterianas. O valor percentual de aditivo demonstrou ser um fator positivo na reduçao do tempo de morte bacteriana quando avaliada a bactéria S. aureus. A análise estatística mostrou que há diferença significativa entre o filme de Ecoflex® puro e os filmes obtidos com diferentes percentuais de MCs-Zn após 24 h de análise e que nao há diferença estatística entre os aditivos antimicrobianos após 24 h de análise. Através da Figura 5 foi possível verificar que tanto para 1% (m/m) quanto para 2% (m/m) de MCs-Zn após 24 h de contato do filme polimérico com a bactéria E. coli ocorreu 100±0% da morte celular, mostrando-se como potencial agente antimicrobiano. Novamente, o efeito antimicrobiano foi menor ao longo do tempo para E. coli quando comparado a S. aureus, fato este já esperado devido a diferença na parede celular dessas bactérias. Verificou-se, ainda, um grande desvio padrao amostral para o filme polimérico aditivado com 1% de MCs-Zn. Este fato deve-se, possivelmente, à inibiçao nao uniforme dos microrganismos na superfície do filme. A partir da análise estatística verificou-se que há diferença significativa para o efeito antibacteriano entre o filme de Ecoflex® puro e os filmes obtidos com diferentes percentuais de MCs-Zn após 24 h de análise, e que nao há diferença significativa entre os aditivos antimicrobianos quando testados frente à bactéria gram-negativa E. coli. Kirschner et al.8 estudaram a incorporaçao do masterbatch de PEBD/microcápsulas de vidro dopadas com zinco iônico em PA6 e testaram sua atividade antimicrobiana frente à S. typhimurium e S. aureus. Quando avaliada a atividade antimicrobiana do masterbatch de PEBD/microcápsulas de vidro dopadas com zinco iônico em PA6 frente à S. typhimurium verificou-se que para o maior percentual de masterbatch (4%) os efeitos antibacterianos foram mais pronunciados. Para S. aureus a análise mostrou que a placa de PA6-PEBD/microcápsulas de vidro dopadas com zinco iônico tem excelente atividade antimicrobiana em ambos os percentuais de masterbatch testados (2 e 4%). Os autores concluíram que mesmo em pequenos percentuais do masterbatch, o efeito antibacteriano foi significativo frente a S. aureus, sendo que um maior percentual era necessário para causar o mesmo efeito contra S. typhimurium, corroborando o fato da diferença na parede celular dessas bactérias, haja vista que S. typhimurium é uma estirpe gram-negativa, análoga à E. coli. Ainda, através da análise estatística, verificou-se que para a bactéria S. aureus nao houve diferença significativa entre os aditivos, bem como entre os diferentes percentuais de aditivos avaliados no tempo de 24 h. Para E. coli, o percentual de 1% (m/m) de NPs-ZnO diferiu estatisticamente de 2% (m/m) de NPs-ZnO e 1 e 2% (m/m) de MCs-Zn no tempo de 24 h, apresentando-se com um efeito de inibiçao ou morte menos pronunciado quando comparado aos demais. Logo, para a inibiçao da bactéria gram-positiva S. aureus após 24 h é indiferente o aditivo antimicrobiano e o percentual de massa utilizado. Desta forma, pode-se optar pela menor concentraçao de aditivo que é de 1% (m/m), o que é menos custoso e pelas MCs-Zn, que possuem a vantagem de nao ser obtidas pela tecnologia nano, que possuem um pré-conceito em torno da sua forma de obtençao. Para a bactéria gram-negativa E. coli, pode-se optar também pela utilizaçao de 1% (m/m) de MCs-Zn em virtude de que após 24 h de contato com o filme polimérico, estas ocasionaram a morte de 100% das bactérias, mesmo efeito observado para 2% (m/m) e, também por este ser mais eficiente quando comparado as NPs-ZnO. Ainda, as MCs-Zn distribuem-se mais uniformemente na matriz polimérica quando comparadas às NPs-ZnO, que formam aglomerados prejudicando desta forma a atividade antimicrobiana, conforme pode ser observado na Figura 6.
 Figura 6. MMicrografias obtidas com microscopia eletrônica de varredura FEG. (a) Filme de Ecoflex® contendo 1% (m/m) de MCs-Zn (b) detalhes de bastoes de Ecoflex® formados nos filmes contendo MCs-Zn, (c) Filme de Ecoflex ® contendo 1% (m/m) de NPs-ZnO (d) detalhes dos aglomerados formados pelas NPs-ZnO e defeitos induzidos no filme de Ecoflex®.
A Figura 6a mostra detalhes de um filme de Ecoflex® contendo 1 % (m/m) de MCs-Zn. Nas regioes R1 e R2 sao mostrados detalhes de aglomerados com dimensoes de 5 a 10 micrometros formados com as microcápsulas. Ao longo do filme é possível observar as micropartículas distribuídas na superfície do Ecoflex®, com dimensoes de aproximadamente 1-2 micrometros. Também sao observadas estruturas orientadas na forma de bastoes, distribuídas ao longo da superfície do filme. A formaçao de aglomerados constituídos por NPs-ZnO é evidente na micrografia apresentada na Figura 6c. Ao longo do filme de Ecoflex® sao formados aglomerados de dimensoes variadas entre 5 e 10 micrometros, porém em maior quantidade que nos filmes de Ecoflex® contendo MCs-Zn, regioes de R3-R6. Com a incorporaçao das NPs-ZnO nao sao formadas as estruturas organizadas ao longo da superfície do filme, o que demostra que a presença das NPs-ZnO influencia na cristalinidade do Ecoflex®. A Figura 6b mostra detalhes do filme de Ecoflex® contendo MCs-Zn. Sao observadas em detalhes as estruturas cristalinas do Ecoflex® na forma de bastoes e a ausência de defeitos significativos no filme. Na Figura 6d sao observados detalhes dos aglomerados constituídos por NPs-ZnO e a formaçao de defeitos no filme de Ecoflex® devido a presença destes aglomerados. Biodegradaçao O solo utilizado no ensaio de biodegradaçao apresentou as seguintes especificaçoes: umidade de 25,91±0,13%, capacidade de retençao de água do solo atual 67,7±0,12%, nitrogênio 0,20%, carbono orgânico 1,68% e relaçao C/N de 8. A quantidade de CO2 total produzida por cada filme polimérico obtido (com e sem aditivos), bem como a quantidade de CO2 produzida para uma amostra controle, que corresponde somente ao solo (sem adiçao do polímero), após 90 dias de teste de biodegradaçao, estao apresentadas nas Figuras 7 e 1S.
 Figura 7. Evoluçao da quantidade de CO2 gerada durante os 90 dias de análise para os polímeros obtidos com e sem NPs-ZnO
Ao analisar as Figuras 7 e 1S (material suplementar) verifica-se que todos os filmes poliméricos e o branco (solo sem polímero) produziram uma quantidade muito semelhante de CO2. Através da análise estatística verificou-se que os filmes poliméricos nao diferem entre si quanto à produçao de CO2, inferindo que a adiçao de diferentes concentraçoes de NPs-ZnO e de MCs-Zn nao afetaram na biodegradaçao do Ecoflex®. Também se verificou que os filmes poliméricos com e sem aditivo nao diferiram quanto à quantidade de CO2 produzida quando comparados ao solo sem o polímero. Casarin et al.39 avaliaram o processo de biodegradaçao em solo do Ecoflex® e verificaram após 90 dias uma perda de massa de 3,27 ± 0,21%. Šerá et al.40 estudaram a biodegradaçao do Ecoflex® puro em solo sob condiçoes aeróbicas a 25 °C, sendo que o referido polímero apresentou uma biodegradaçao muito limitada, atingindo um nível geral de mineralizaçao de cerca de 7% após 100 dias de incubaçao. Saadi et al.41 obtiveram 10% degradaçao do PBAT após 75 dias de incubaçao em solo à 30 °C inferindo que em condiçoes muito semelhantes às utilizadas no presente estudo o Ecoflex® nao sofre degradaçao, sendo necessárias condiçoes muito específicas, como por exemplo, a compostagem, para que de fato esse polímero se degrade em um curto espaço de tempo. De acordo com a BASF, o Ecoflex® atinge mais de 90% de conversao de carbono em CO2 depois de apenas 80 dias de análise em compostagem. De acordo com Mohanty e Nayak,42 o PBAT sofre biodegradaçao sob condiçoes de compostagem, atingindo 80% de biodegradaçao em 180 dias. Muniyasamy et al.43 observaram um comportamento de degradaçao semelhante, onde a taxa de biodegradaçao foi cerca de 90% em um período de 180 dias sob condiçoes de compostagem. Na Figura 2S (material suplementar) encontram-se as imagens dos filmes poliméricos obtidas com auxílio de um estereomicroscópio com aumento de 50 vezes em 0 dias (a) e após 90 dias de ensaio de biodegradaçao (b). Ao analisar a Figura 2S (material suplementar) é possível perceber que nao há diferenças entre os filmes poliméricos nos tempos de 0 e 90 dias de ensaio, corroborando o fato de que nao ocorreu a biodegradaçao dos mesmos nas condiçoes estudadas. É perceptível a presença de alguns pontos escuros nos filmes poliméricos aditivados com 1 e 2% (m/m) de MCs-Zn, sendo possivelmente as microcápsulas distribuídas na matriz do polímero biodegradável, já que esse fato nao é observado para os filmes aditivados com as NPs-ZnO. Ainda, percebem-se claramente as linhas de orientaçao de máquina, entretanto, nenhum indicativo de degradaçao, como fissuras, trincas ou ranhuras sao observados. O presente trabalho foi realizado sem aeraçao, sob temperatura próxima à ambiente e sem umidade do ar e do solo controladas, logo, as taxas de biodegradaçao sao menores e, consequentemente, o tempo de 90 dias foi insuficiente para que a mineralizaçao de toda a amostra acontecesse.
CONCLUSOES Através deste estudo pode-se concluir que pela adiçao das NPs-ZnO e das MCs-Zn ao polímero biodegradável Ecoflex® foi possível agregar a atividade antimicrobiana aos filmes poliméricos sem comprometer sua degradabilidade. Dentre os aditivos antimicrobianos e os percentuais destes estudados, pode-se optar pela concentraçao de 1% (m/m), visto que esta apresenta resultados estatisticamente semelhantes após 24 horas de contato do filme poliméricos com as bactérias à concentraçao de 2% (m/m), diminuindo desta forma custos para a obtençao dos filmes antimicrobianos, e pela utilizaçao das MCs-Zn devido à vantagem de nao serem sintetizadas pela tecnologia nano, a qual possui um pré-conceito em torno da sua forma de obtençao e pelo fato de nao se saber ao certo quais os possíveis danos por elas causados nos organismos vivos e ainda, pela distribuiçao mais homogênea na matriz polimérica se comparadas às NPs-ZnO.
MATERIAL SUPLEMENTAR No material suplementar, disponível gratuitamente em http://quimicanova.sbq.org.br, na forma de PDF, estao apresentados, a Figura 1S que mostra a evoluçao da quantidade de CO2 gerada durante os 90 dias do ensaio de biodegradaçao para os polímeros obtidos com e sem MCs-Zn, bem como as imagens dos filmes poliméricos obtidas com auxílio de um estereomicroscópio com aumento de 50 vezes em 0 dias (a) e após 90 dias de ensaio de biodegradaçao (b) (Figura 2S).
AGRADECIMENTOS Os autores agradecem à Unochapecó pela estrutura disponibilizada para a realizaçao deste trabalho. Agradecem também à CAPES pelo suporte financeiro. A BASF e Kher Group pelo fornecimento dos materiais utilizados na pesquisa.
REFERENCIAS 1. Sharma, C.; Dhiman, R.; Rokana, N.; Panwar, H.; Front.Microbiol. 2017, 8, 1. 2. Appendini, P.; Hotchkiss, J. H.; Innovative Food Sci. Emerging Technol. 2002, 3, 113. 3. Soares, N. F. F.; Silva, W. A.; Pires, A. C. S.; Camilloto, G. P.; Silva, P. S.; Rev. Ceres 2009, 56, 370. 4. Espitia, P. J. P.; Soares, N. F. F.; Coimbra, J. S. R.; Andrade, N. J.; Cruz, R. S.; Medeiros, E. A. A.; Food Bioprocess Technol. 2012, 5, 1447. 5. Droval, G.; Aranberri, I.; Germán, L.; Ivano, E.; Dimitrova, E.; Kotsilkova, R.; Verelst, M.; Ghys, J. D.; J. Thermoplast. Compos. 2014, 27, 268. 6. Sirelkhatim, A.; Mahmud, S.; Seeni, A.; Kaus, N. H. M.; Ann, L. C.; Bakhori, S. K. M.; Hasan, H.; Mohamad, D.; Nano Micro Lett. 2015, 7, 219. 7. Santos, M. F.; Machado, C.; Tachinski, C. G.; Fiori Júnior, J.; Piletti, R.; Peterson, M.; Fiori, M. A.; Mater. Sci. Eng. C 2014, 39, 403. 8. Kirschner, M. R. C.; Rippel, T.; Ternus, R. Z.; Duarte, G. W.; Riella, H. G.; Dal Magro, J.; Mello, J. M. M.; Silva, L. L.; Fiori, M. A.; J. Appl. Polym. Sci. 2017, 134, 1. 9. Dagostin, V. S.; Golçalves, D. L.; Pacheco, C. B.; Almeida, W. B.; Thomé, I. P.; Pich, C. T.; Paula, M. M. S.; Silva, L.; Angioletto, E.; Fiori, M. A.; Mater. Sci. Eng. C 2010, 30, 705. 10. Xie, Y.; He, Y.; Irwin, P. L.; Jin, T.; Shi, X.; Appl.Environ. Microb. 2011, 77, 2325. 11. Moezzi, A.; McDonagh, A. M.; Cortie, M. B.; Chem. Eng. J. 2012, 185-186, 1. 12. Doumbia, A. S.; Vezin, H.; Ferreira, M.; Campagne, C.; Devaux, E.; J.Appl. Polym. Sci. 2015, 132, 1. 13. Smijs, T. G.; Pavel, S.; Nanotechnol. Sci. Appl. 2011, 4, 95. 14. Tankhiwale, R.; Bajpai, S. K.; Colloids Surf. B 2012, 90, 16. 15. Othman, S. H.; Salam, N. R. A.; Zainal, N.; Basha, R. K.; Talib, R. A.; Int. J. Photoenergy 2014, 2014, 1. 16. Emamifar, A.; Mohammadizadeh, M.; Food Technol. Biotechnol. 2015, 53, 488. 17. Beigmohammadi, F.; Peighambardoust, S. H.; Hesari, J.; Azadmard-Damirchi, S.; Peighambardoust, S. J.; Khosrowshahic, N. K.; LWT - Food Sci. Technol. 2015, 66. 18. Esmailzadeh, H.; Sangpour, P.; Shahraz, F.; Hejazi, J.; Khaksar, R.; Mater. Sci. Eng. C 2016, 1, 1058. 19. Marcous, A.; Rasouli, S.; Ardestani, F.; Journal of Particle Science and Technology 2017, 3, 1. 20. Kijchavengkul, T.; Auras, R.; Rubino, M.; Selke, S.; Ngouajio, M.; R. Fernandez, T.; Polym. Degrad. Stabil. 2010, 95, 241. 21. http://www.plasticsportal.net/wa/plasticsEU~ru_RU/portal/show/content/products/biodegradable_plastics/ecoflex, acessada em janeiro de 2018. 22. Ma, P.; Jiang, L.; Yu, M.; Dong, W.; Chen, M.; ACS Sustainable Chem. Eng. 2016, 4, 6417. 23. Venkatesan, R.; Rajeswari, N.; Polym. Adv. Technol. 2017, 28, 1699. 24. Venkatesan, R.; Rajeswari, N.; Polym. Adv. Technol. 2017, 28, 20. 25. Díez-Pascual, A. M.; Díez-Vicente, A. L.; ACS Appl. Mater. Interfaces 2014, 6, 3729. 26. Castro-Mayorga, J. L.; Fabra, M. J.; Lagaron, J. M.; Innovative Food Sci. Emerging Technol. 2016, 33, 524. 27. Rodríguez-Tobías, H.; Morales, G.; Ledezma, A.; Romero, J.; Saldívar, R.; Langlois, V.; Renard, E.; Grande, D.; J. Mater. Sci. 2016, 51, 8593. 28. Marra, A.; Silvestre, C.; Duraccio, D.; Cimmino, S.; Int. J. Biol. Macromol. 2016, 88, 254. 29. Clinical and Laboratory Standards Institute; Performance standards for antimicrobial disk susceptible tests; Approved standard - Eleventh Edition. CLSI document M02-A11. Wayne, Pennsylvania, 2012. 30. JIS Z 2801:2010. Antibacterial products - Test for antibacterial activity and efficacy, 2010. 31. American Society for Testing and Materials; ASTM D-5988-12. Standard Test Method for Determining Aerobic Biodegradation of Plastic Materials in Soil, 2012. 32. Americam Society for Testing and Materials; ASTM D5338 - 11 - Standard test method for determining aerobic biodegradation of plastic materials under controlled composting conditions, incorporating thermophilic temperatures, 2011. 33. Mariani, P. D. S. C.; Vinagre Neto, A. P.; da Silva Jr., J. P.; Cardoso, E. J. B. N.; Esposito E.; Innocentini-Mei, L. H.; J. Polym. Environ. 2007, 15, 19. 34. International Organization for Standartization; Determination of the water-holding capacity. ISO 17512. Genebra, Switzerland: ISO, 2011. 35. Morita, T.; Assumpçao, R. M. V.; Manual de soluçao, reagentes e solventes: padronizaçao, preparaçao, purificaçao, Edgard Blucher: Sao Paulo, 2005. 36. Muñoz-Bonilla, A.; Fernández-García, M.; Prog. Polym. Sci. 2012, 37, 281. 37. Sonohara, R.; Muramatsu, N.; Ohshima, H.; Kondo, T.; Biophys. Chem. 1995, 55, 273. 38. Gordon, T.; Perlstein, B.; Houbara, O.; Felner, I.; Banin, E.; Margel, S.; Colloids Surf. A 2011, 374, 1. 39. Casarin, S. A.; Agnelli, J. A. M.; Malmonge, S. M.; Rosário, F.; Polímeros 2013, 23, 115. 40. Šerá, J.; Stloukal, P.; jančová, P.; Verney, V.; Pekařová, S.; Koutny, M.; J. Agr. Food Chem. 2016, 64, 5653. 41. Saadi, Z.; Cesar, G.; Bewa, H.; Benguigui, L.; J. Polym. Environ. 2013, 21, 893. 42. Mohanty, S.; Nayak, S. K.; J. Polym. Environ. 2012, 20, 195. 43. Muniyasamy, S.; Reddy, M. M.; Misra, M.; Mohanty, A.; Ind. Crop. Prod. 2013, 43, 812.
# Programa de Pós-Graduaçao em Ciências Ambientais |
On-line version ISSN 1678-7064 Printed version ISSN 0100-4042
Qu�mica Nova
Publica��es da Sociedade Brasileira de Qu�mica
Caixa Postal: 26037
05513-970 S�o Paulo - SP
Tel/Fax: +55.11.3032.2299/+55.11.3814.3602
Free access





